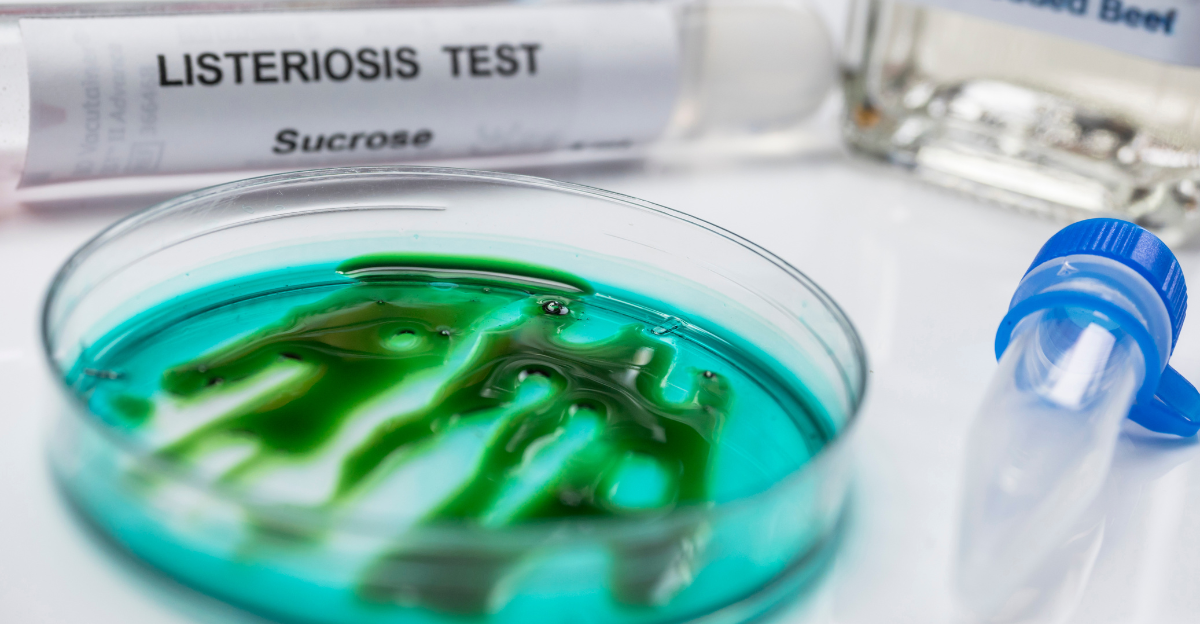

A crucial public health measure is the USDA’s recent warning about Listeria contamination in ham products. Listeria monocytogenes is a harmful bacterium that causes listeriosis, a severe infection that is mainly spread by contaminated food. Meningitis, septicemia, miscarriage, or death are among the serious consequences of this illness, which primarily affects pregnant women, infants, the elderly, and people with compromised immune systems.
The Food Safety and Inspection Service (FSIS) of the USDA released a public health alert in 2025 about ham salad products that were ready to eat but contained recalled breadcrumbs that were tainted with Listeria. By warning the public even when the tainted ingredient is present in a product rather than the product itself, this action demonstrates USDA’s proactive approach to food safety.
The Historical Background of Food Safety and Listeria

Significant morbidity and mortality have been known to result from listeria outbreaks; early noteworthy cases include the 1985 outbreak connected to Mexican-style soft cheese, which claimed over 50 lives. The pathogen has become a significant concern over the years, especially in relation to dairy and ready-to-eat meat. Infections caused by serotype 4b became more common in meat and dairy products during the 1990s and 2000s, replacing produce-related outbreaks.
Due to Listeria’s historical persistence in food supplies, strict regulatory frameworks, including improved testing procedures and in-depth outbreak investigations, have become necessary. These actions highlight the pathogen’s cunning; it frequently contaminates food without being noticed until outbreaks happen, and show why food safety officials need to be on the lookout and proactive.
Trends in Listeria Contamination in 2025

Listeria contamination and recalls have significantly increased in 2025, exposing flaws in food production systems while also demonstrating advancements in detection technology. The scope of contamination risks is highlighted by large recalls such as the 7 million-pound Boar’s Head deli meat incident. Early in 2025, the USDA implemented improved testing procedures with the goal of detecting Listeria presence earlier, which could lead to more recalls but ultimately improve food safety.
The FDA-recalled breadcrumbs used in the ham salad recall this year are a prime example of the complexity of the supply chain, as contamination in one ingredient can spread risks to several product lines. The pattern indicates a time when preventive recalls are crucial for public health even though they can be disruptive.
Difficulties in Managing Listeria

Because of its biology, Listeria presents special difficulties because it can live on surfaces and equipment, grow in cold environments like refrigerators, and contaminate a wide range of foods after processing. For manufacturers, these characteristics make eradication efforts more difficult. As evidenced by USDA inspection records demonstrating noncompliance at contaminated plants, deficiencies like unhygienic equipment conditions, condensation, and cross-contamination during processing have been frequently connected to outbreaks.
Because sporadic cases of listeriosis are asymptomatic, tainted food can spread widely before being discovered. Furthermore, traceability and quick response are made more difficult by the fragmentation of suppliers and ingredients, as was the case with the recalled contaminated breadcrumbs used in ham salad.
Special Perspectives: Inter-Industry Difficulties

An unanticipated cross-industry risk that combines meat processing with bakeries and ingredient suppliers is the contamination of ham products by breadcrumbs. Reliance on supply chains with multiple suppliers and ingredients makes them vulnerable, as a single supplier’s failure could jeopardize entire product categories.
Because of this interdependence, integrated food safety systems that go beyond conventional industry silos are required. It also calls into question monitoring technologies, liability distribution, and the ability of regulatory bodies to effectively monitor intricate supply chains, particularly when ingredients are regulated by both the FDA and USDA.
Divergent Opinions Regarding USDA Alerts

Regular recalls and alerts, according to some detractors, can cause consumer panic, undermine trust in regulatory bodies, and inflict undue financial harm on manufacturers and retailers. Whether “fear-based” messaging could backfire by bombarding consumers with safety warnings for minor hazards is up for debate.
The argument, however, is based on the moral requirement and long-term advantages of openness and prevention. USDA alerts that are effectively conveyed empower consumers to make knowledgeable decisions and enforce industry responsibility, which strengthens rather than weakens the culture of food safety.
Divergent Opinions Regarding USDA

Alerts Regular recalls and alerts, according to some detractors, can cause consumer panic, undermine trust in regulatory bodies, and inflict undue financial harm on manufacturers and retailers. Whether “fear-based” messaging could backfire by bombarding consumers with safety warnings for minor hazards is up for debate.
The argument, however, is based on the moral requirement and long-term advantages of openness and prevention. USDA alerts that are effectively conveyed empower consumers to make knowledgeable decisions and enforce industry responsibility, which strengthens rather than weakens the culture of food safety.
Multi-Agency Coordination and Regulatory Dynamics

The cooperation between the FDA and USDA exemplifies the regulatory complexity of contemporary food safety. Coordination is necessary during recalls involving cross-jurisdictional ingredients, such as breadcrumbs in ham salad, because each agency regulates distinct products and ingredients.
In order to facilitate thorough tracking and prompt public alerts, this collaborative oversight necessitates coordinated communication tactics and shared databases. As supply chains become more complex and the risks of product contamination change, it will be essential to improve data sharing technologies and strengthen interagency frameworks.
Effects of Food Recalls on Consumers’ Minds

Consumers may become more concerned about food safety as a result of repeated USDA alerts, which may cause them to avoid particular food categories and mistrust food brands. These psychological reactions could influence dietary decisions and public health nutrition trends by extending to more general food attitudes.
To stop irrational fear reactions, transparent communication techniques that prioritize context and risk reduction are crucial. Regulators and business can effectively frame alerts by balancing urgency and reassurance to preserve trust by having a thorough understanding of consumer psychology.
Economic Repercussions of Recalls

The production, retail, and healthcare industries all bear a heavy financial burden from food recalls, especially the well-publicized USDA alerts on Listeria. Operational disruptions, legal liabilities, and product destruction are examples of direct costs. Reduced consumer confidence and brand damage result in indirect costs. For instance, the massive meat recall in 2024 required the disposal of millions of pounds of product.
However, the lives saved and the avoided healthcare costs outweigh these short-term financial hardships, supporting strict recall laws as investments in both economic stability and societal well-being.
Historical Accounts of the Development of Regulation
The USDA’s increased attention to Listeria is an example of how regulations have changed over decades in response to previous outbreaks. Because there was insufficient testing for this pathogen in the 1980s and 1990s, outbreaks and fatalities were common.
As time went on, science-based policies combined food processing laws with pathogen surveillance, demonstrating a change from reactive to preventive paradigms. This developed regulatory ecosystem is the source of today’s recalls, such as the ham salad recall, which combines lessons learned from past mistakes with new technology.
Consumer Education’s Function

A key component of prevention is educating consumers about the dangers of Listeria and how to handle food safely. The USDA’s alerts serve as both educational resources and recalls, advising consumers to steer clear of dangerous goods.
Because Listeria can grow in foods that are ready to eat and survive cold storage, it is crucial to educate people about good hygiene, refrigeration, and timely disposal during recalls in order to reduce illness. Recall announcements combined with public awareness campaigns may improve food safety results.
Technology and Supply Chain Transparency

Blockchain technology and digital traceability systems have the potential to revolutionize the way that Listeria outbreaks are handled. Finding the source of contamination can be sped up with real-time ingredient tracking from source to shelf. Increased transparency lowers the possibility of tainted products reaching the market by forcing processors and suppliers to follow strict safety regulations.
The contamination of the ham salad breadcrumb serves as an example of the dangers posed by opaque supply chains, a problem that contemporary transparency tools seek to address.
Theories Regarding the Evolution of Listeria

Questions concerning Listeria’s changing resistance and adaptability in industrial food environments are raised by its growing detection and apparent prevalence. According to some theories, Listeria strains might be developing improved biofilm formation or survivability traits against sanitizers, which would make eradication more difficult.
Underpinning next-generation food safety strategies, these theoretical considerations highlight the need for ongoing pathogen genomics research and the creation of innovative antimicrobials.
Unexpected Epidemiological Information

Despite being rare in comparison to other foodborne pathogens, Listeria disproportionately causes foodborne deaths, contributing to about 260 deaths annually in the United States despite only 1,600 cases.
The critical nature of USDA alerts and recalls is highlighted by the high case-fatality rate that sets Listeria apart from pathogens such as Salmonella. Further evidence that widespread low-level contamination necessitates systematic vigilance rather than reactive measures alone comes from the fact that many cases are intermittent and unrelated to outbreaks.
The Wider Effects on Society

Listeria recalls have an impact on social trust, corporate responsibility, and regulatory legitimacy in addition to health and the economy. Voting, policy advocacy, and consumer activism can all be influenced by public awareness of food safety.
There is increasing pressure on food companies to operate in a transparent and sustainable manner. Thus, the USDA’s ham salad warning. Beyond the immediate prevention of illness, Listeria contamination represents a complex socio-technical challenge affecting various societal dimensions.
Prospects for the Future and Predictive Knowledge

In the future, Listeria control will be defined by interdisciplinary approaches that combine genomics, data analytics, behavioral science, and regulatory innovation. Advanced pathogen detection combined with automation in food production promises early warnings.
However, if regulatory harmonization is delayed, growing globalized supply chains may also increase the risk of contamination. Proactive recalls can be facilitated by predictive risk modeling, which can transform emergencies like the current ham alert into teaching moments for creating resilient food systems.
In Conclusion

A crucial, proactive public health measure that takes into account historical lessons, scientific discoveries, and changing consumer and regulatory expectations is the USDA’s warning about Listeria contamination in ham. These recalls indicate a developing food safety culture while averting serious disease outcomes, despite psychological and financial difficulties.
USDA’s early warnings and improved testing procedures in 2025 represent the best defense as contamination risks become more complex due to supply chain interdependencies, safeguarding vulnerable populations and restoring confidence in the integrity of the food system.